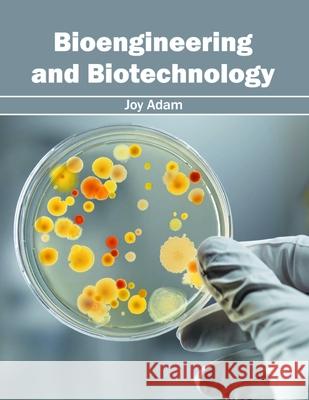
Bioengineering and Biotechnology Joy Adam 9781632397492 Callisto Reference - książka

Bioengineering and Biotechnology » książka
topmenu
Bioengineering and Biotechnology
ISBN-13: 9781632397492 / Angielski / Twarda / 2016 / 280 str.
Kategorie:
Kategorie BISAC:
Wydawca:
Callisto Reference
Język:
Angielski
ISBN-13:
9781632397492
Rok wydania:
2016
Dostępne języki:
Angielski
Ilość stron:
280
Waga:
0.94 kg
Wymiary:
27.927.9 x 21.627.9 x 21.6 x 1
Oprawa:
Twarda
Wolumenów:
01